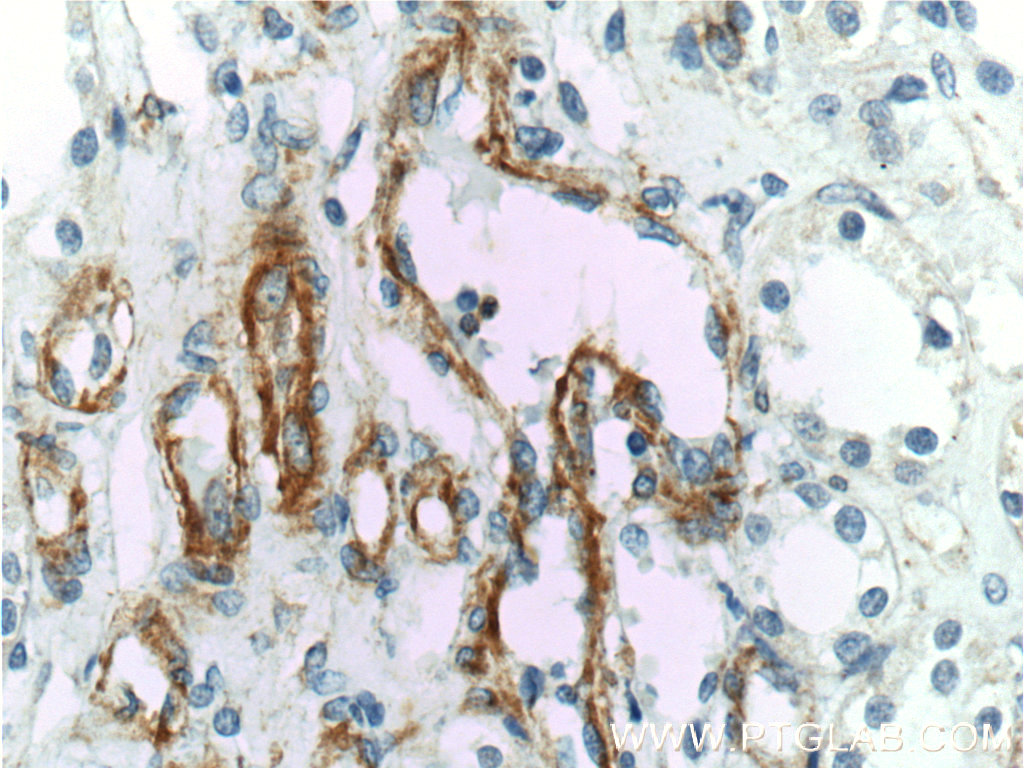
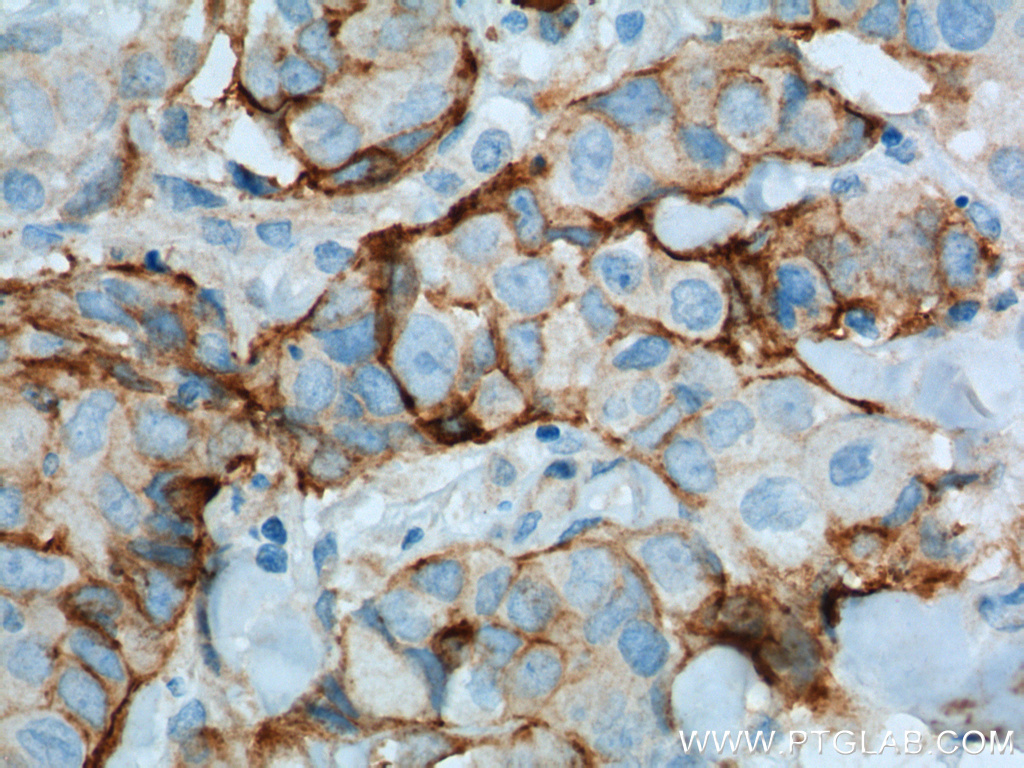

验证数据展示
经过测试的应用
| Positive WB detected in | TNF alpha treated HUVEC cells |
| Positive IHC detected in | human tonsillitis tissue, human kidney tissue, human spleen tissue, human placenta tissue, human lung cancer tissue Note: suggested antigen retrieval with TE buffer pH 9.0; (*) Alternatively, antigen retrieval may be performed with citrate buffer pH 6.0 |
推荐稀释比
| 应用 | 推荐稀释比 |
|---|---|
| Western Blot (WB) | WB : 1:500-1:2000 |
| Immunohistochemistry (IHC) | IHC : 1:400-1:1600 |
| It is recommended that this reagent should be titrated in each testing system to obtain optimal results. | |
| Sample-dependent, Check data in validation data gallery. | |
产品信息
11444-1-AP targets VCAM-1/CD106 in WB, IHC, IF, ELISA applications and shows reactivity with human samples.
| 经测试应用 | WB, IHC, ELISA Application Description |
| 文献引用应用 | WB, IHC, IF |
| 经测试反应性 | human |
| 文献引用反应性 | human |
| 免疫原 |
CatNo: Ag1993 Product name: Recombinant human VCAM-1 protein Source: e coli.-derived, PGEX-4T Tag: GST Domain: 341-739 aa of BC017276 Sequence: ESPSFSWRTQIDSPLSGKVRSEGTNSTLTLSPVSFENEHSYLCTVTCGHKKLEKGIQVELYSFPRDPEIEMSGGLVNGSSVTVSCKVPSVYPLDRLEIELLKGETILENIEFLEDTDMKSLENKSLEMTFIPTIEDTGKALVCQAKLHIDDMEFEPKQRQSTQTLYVNVAPRDTTVLVSPSSILEEGSSVNMTCLSQGFPAPKILWSRQLPNGELQPLSENATLTLISTKMEDSGVYLCEGINQAGRSRKEVELIIQVTPKDIKLTAFPSESVKEGDTVIISCTCGNVPETWIILKKKAETGDTVLKSIDGAYTIRKAQLKDAGVYECESKNKVGSQLRSLTLDVQGRENNKDYFSPELLVLYFASSLIIPAIGMIIYFARKANMKGSYSLVEAQKSKV 种属同源性预测 |
| 宿主/亚型 | Rabbit / IgG |
| 抗体类别 | Polyclonal |
| 产品类型 | Antibody |
| 全称 | vascular cell adhesion molecule 1 |
| 别名 | VCAM1, VCAM-1, CD106, INCAM 100, INCAM-100 |
| 计算分子量 | 739 aa, 81 kDa |
| 观测分子量 | 110 kDa |
| GenBank蛋白编号 | BC017276 |
| 基因名称 | VCAM-1 |
| Gene ID (NCBI) | 7412 |
| RRID | AB_2214232 |
| 偶联类型 | Unconjugated |
| 形式 | Liquid |
| 纯化方式 | Antigen affinity purification |
| UNIPROT ID | P19320 |
| 储存缓冲液 | PBS with 0.02% sodium azide and 50% glycerol, pH 7.3. |
| 储存条件 | Store at -20°C. Stable for one year after shipment. Aliquoting is unnecessary for -20oC storage. |
背景介绍
Vascular cell adhesion molecule 1 (VCAM1), also known as CD106, is a 110-kDa transmembrane glycoprotein belonging to the immunoglobulin gene superfamily. VCAM1 is expressed by cytokine-activated endothelium, interacts with integrin VLA4 (α4β1) present on the surface of leukocytes, and mediates both adhesion and signal transduction. It is also expressed either constitutively or inducibly in a variety of other cell types, including vascular smooth muscle cells, differentiating skeletal muscle cells, renal and neural epithelial cells, macrophages (Kupffer cells), dendritic cells, and bone marrow stromal cells (PMID: 7507076, 11359843).
实验方案
| Product Specific Protocols | |
|---|---|
| IHC protocol for VCAM-1/CD106 antibody 11444-1-AP | Download protocol |
| WB protocol for VCAM-1/CD106 antibody 11444-1-AP | Download protocol |
| Standard Protocols | |
|---|---|
| Click here to view our Standard Protocols |
发表文章
| Species | Application | Title |
|---|---|---|
Nat Immunol Sparcl1 mitigates abdominal aortic aneurysm through inhibiting lymphangiogenesis-mediated TLS formation | ||
EBioMedicine Interactions between neutrophil extracellular traps and activated platelets enhance procoagulant activity in acute stroke patients with ICA occlusion. | ||
Aging Dis Sterol-resistant SCAP Overexpression in Vascular Smooth Muscle Cells Accelerates Atherosclerosis by Increasing Local Vascular Inflammation through Activation of the NLRP3 Inflammasome in Mice. | ||
ACS Appl Mater Interfaces Inflammation-Driven Nanohitchhiker Enhances Postoperative Immunotherapy by Alleviating Prostaglandin E2-Mediated Immunosuppression | ||
Br J Pharmacol Substitution of the SERCA2 Cys(674) reactive thiol accelerates atherosclerosis by inducing endoplasmic reticulum stress and inflammation |